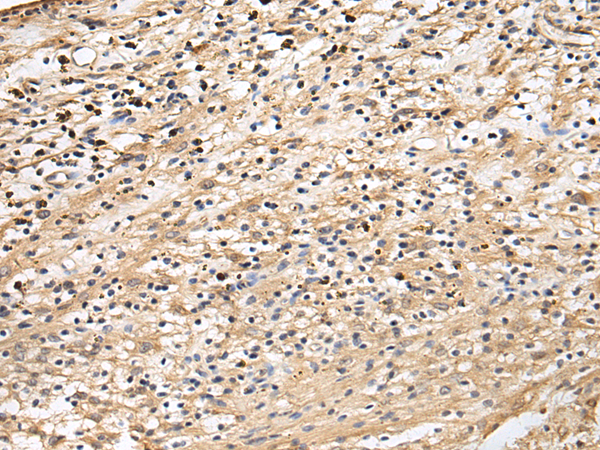

中文名稱: 兔抗CRACR2A多克隆抗體
|
Background: |
Ca2+-binding protein that plays a key role in store-operated Ca2+ entry (SOCE) in T-cells by regulating CRAC channel activation. Acts as a cytoplasmic calcium-sensor that facilitates the clustering of ORAI1 and STIM1 at the junctional regions between the plasma membrane and the endoplasmic reticulum upon low Ca2+concentration. It thereby regulates CRAC channel activation, including translocation and clustering of ORAI1 and STIM1. Upon increase of cytoplasmic Ca2+resulting from opening of CRAC channels, dissociates from ORAI1 and STIM1, thereby destabilizing the ORAI1-STIM1 complex. |
|
Applications: |
ELISA, IHC |
|
Name of antibody: |
CRACR2A |
|
Immunogen: |
Fusion protein of human CRACR2A |
|
Full name: |
calcium release activated channel regulator 2A |
|
Synonyms: |
EFCAB4B |
|
SwissProt: |
Q9BSW2 |
|
ELISA Recommended dilution: |
5000-10000 |
|
IHC positive control: |
Human brain |
|
IHC Recommend dilution: |
50-200 |
購(gòu)物車(chē)
購(gòu)物車(chē) 幫助
幫助
 021-54845833/15800441009
021-54845833/15800441009
